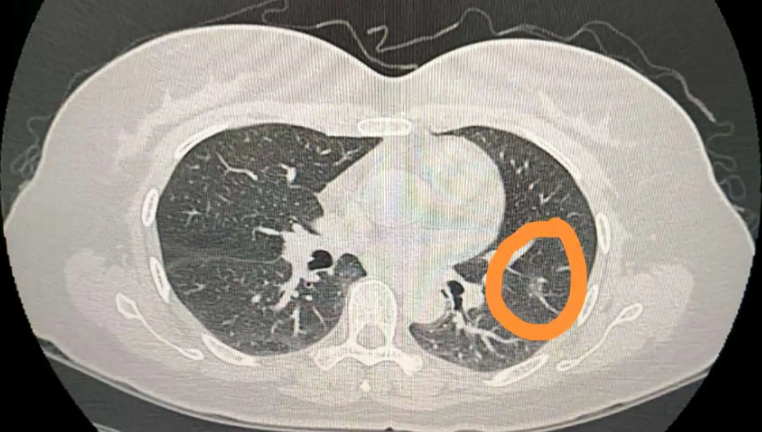
磨玻璃结节

肺部出现6mm磨玻璃结节的原因有很多,可能是肺部炎症、过敏、肺结核或肺部肿瘤引起的。需要及时就诊,了解具体情况再来对症治疗。不要盲目用药,以免加重症状或掩盖病情。
1.肺部炎症:肺部6mm磨玻璃结节可能由肺部炎症引起,如肺部细菌或病毒感染。炎症损害间质性肺并刺激间质性肺的增殖,这导致肺中的毛玻璃结节。一般需要在医生指导下使用消炎药;
2.过敏:如果过敏因素引起的肺部磨玻璃结节为6mm,患者会出现咳嗽、咳痰,甚至呼吸困难。可在医生指导下使用抗过敏药物治疗;
3.肺结核:肺结核临床发生后,由于肺结核是结核杆菌对人体造成的感染,肺部可出现6mm的磨玻璃结节。一般可在医生指导下使用抗结核药物;
4.肺部肿瘤:部分患者有肺部肿瘤疾病。由于肿瘤细胞所在的肺组织形成的结节密度高于正常肺组织,可能导致肺部出现6mm的磨玻璃结节,需要及时进行针对性治疗。早期手术切除可以判断疾病的良恶性程度。如果是恶性肺透明结节,应及时进行放化疗或靶向药物治疗。
5.其他情况:各种肺部疾病,如陈旧性肺部病变、肺纤维化、肺出血等,肺部也可能有6mm的磨玻璃结节。如果没有病变改变,陈旧性肺部病变通常不需要治疗。肺纤维化患者可用糖皮质激素、免疫抑制剂等治疗,肺出血患者需要止血。